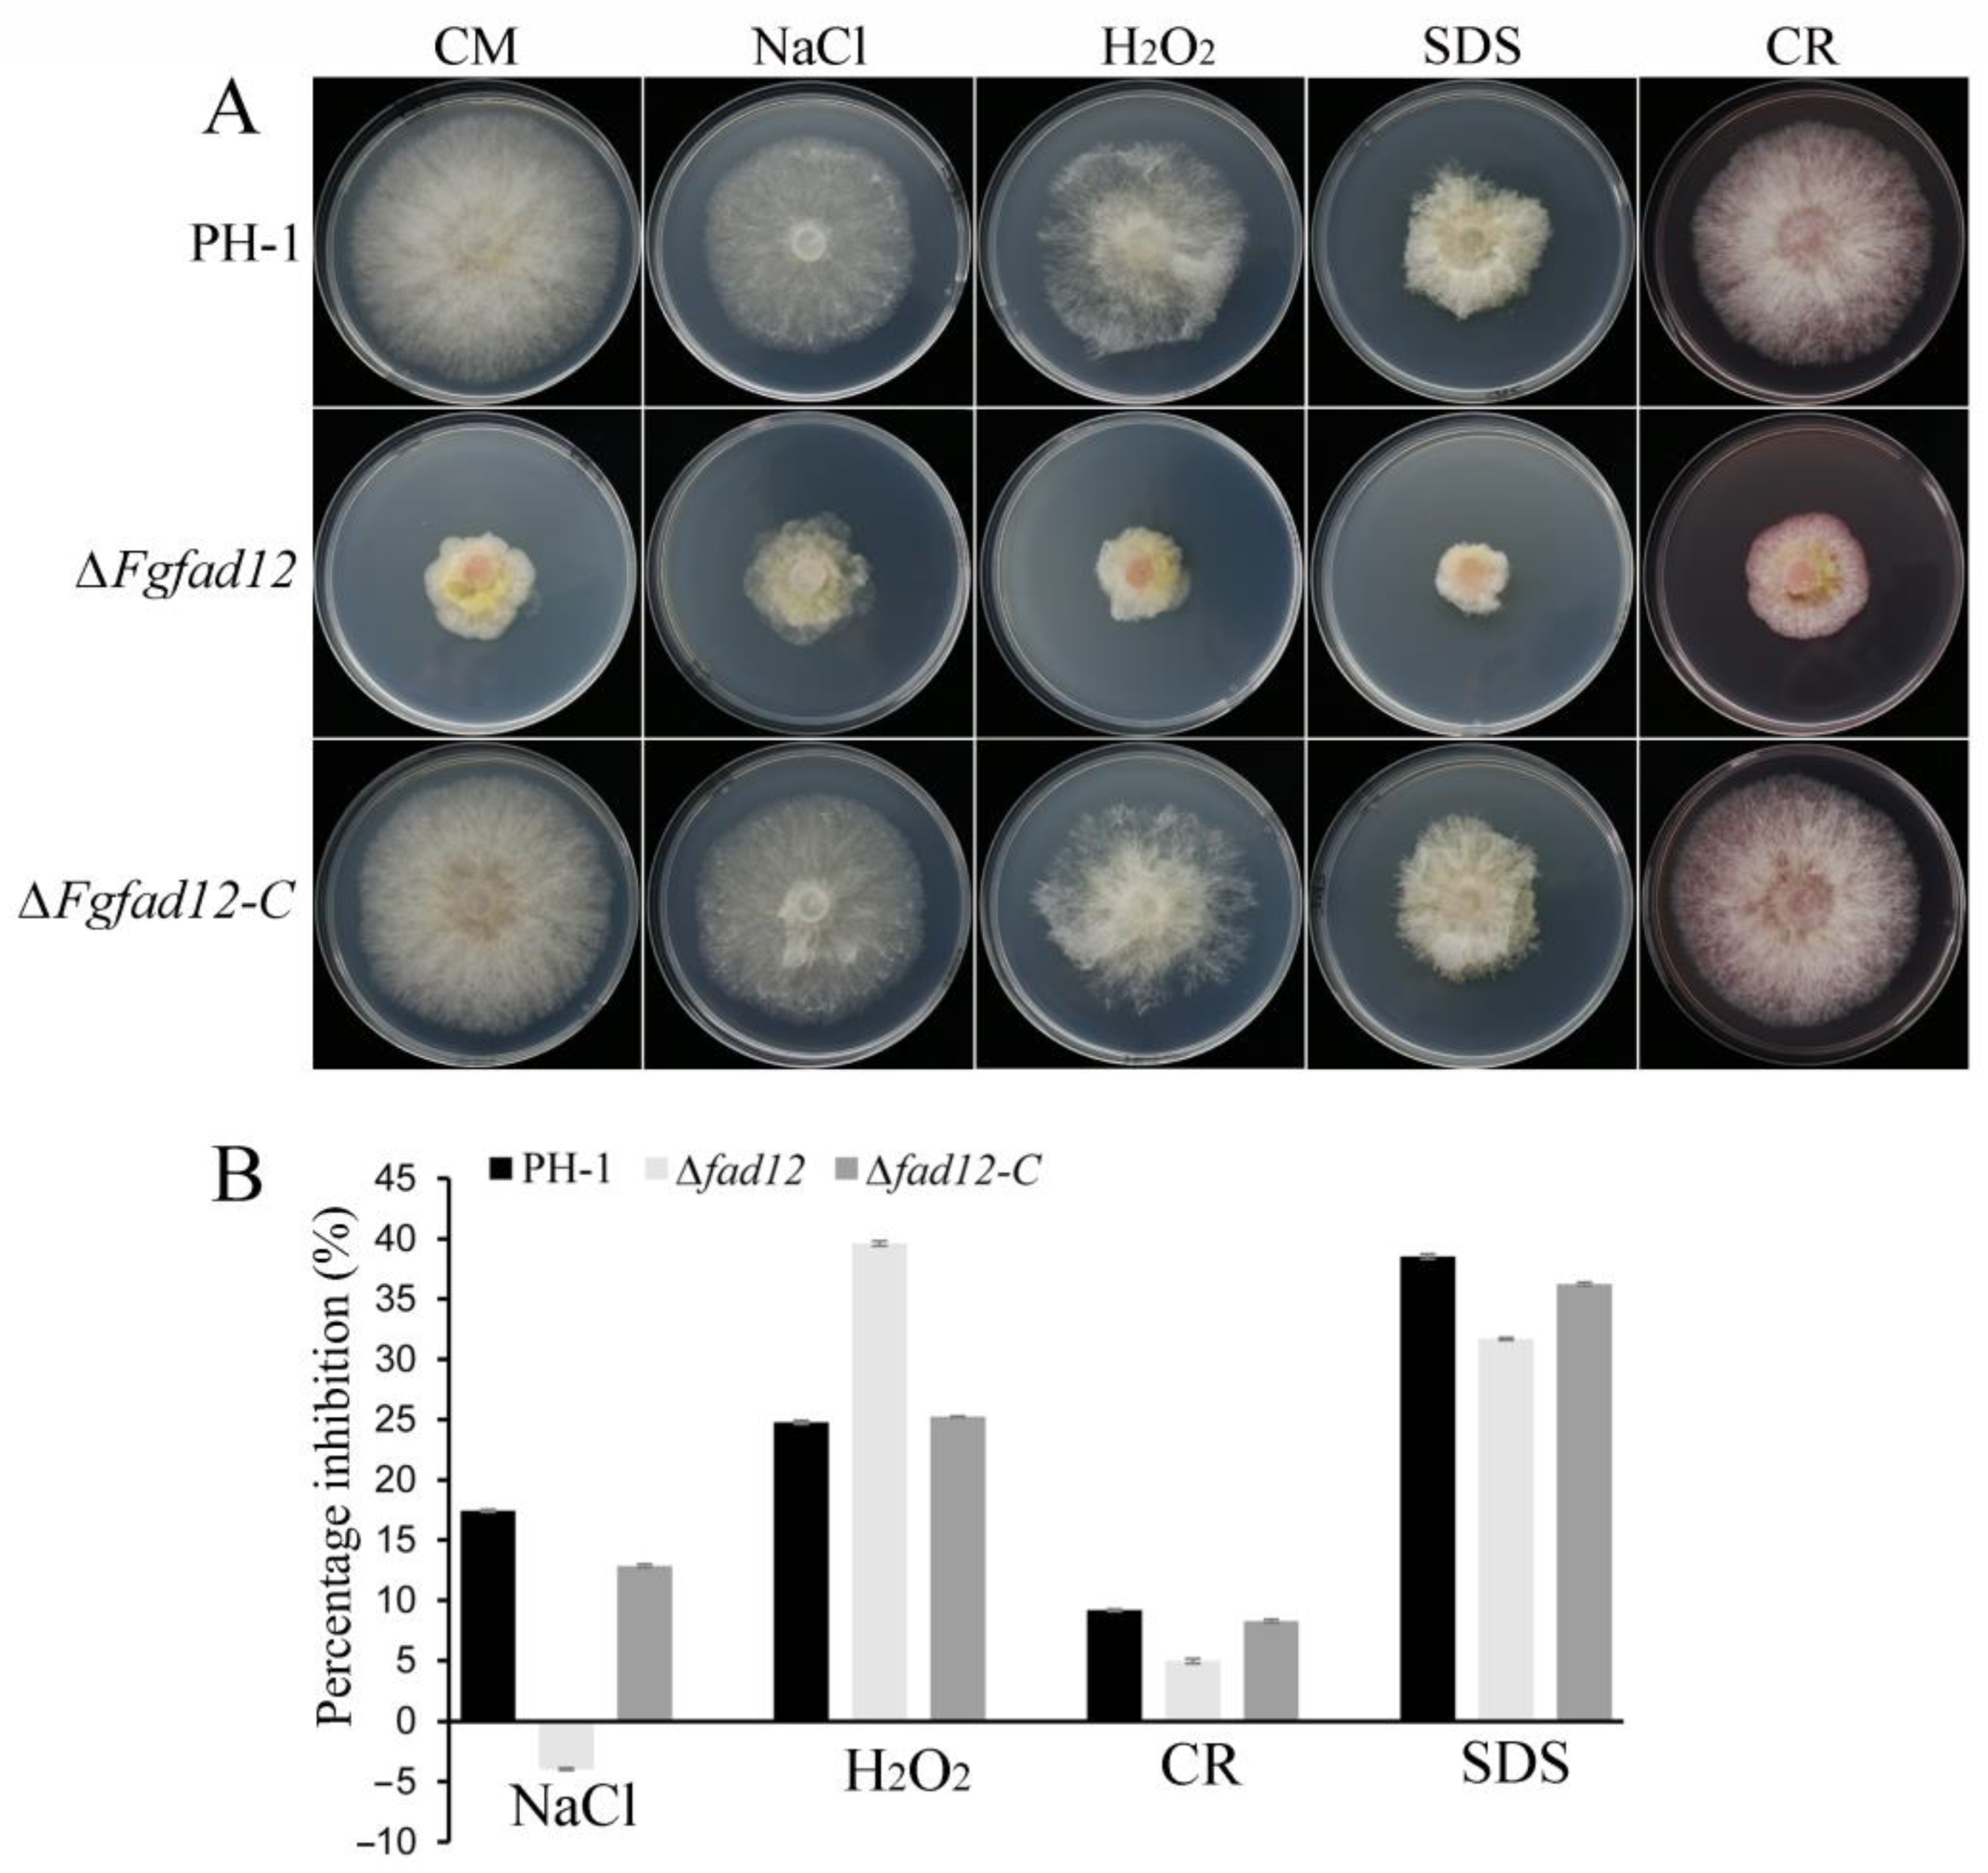
Jof 10 00288 g003 Jof 10 00288 g003

FgFAD12 Regulates Vegetative Growth, Pathogenicity and Linoleic Acid Biosynthesis in Fusarium graminearum
Abstract
1. Introduction
2. Materials and Methods
2.1. Fungal Strains and Culture Conditions
2.2. Generation of Fgfad12 Deletion Mutants
2.3. Generation of the FgFAD12-GFP and Co-Localization Transformants
2.4. Plant Infection Assays and DON Production Assays
2.5. qRT-PCR Assays
2.6. Fatty Acids Analysis
2.7. RNA-seq Analysis
3. Results
3.1. FgFAD12 Is a Delta-12 Fatty Acid Desaturase in F. graminearum
3.2. FgFAD12 Is Required for Vegetative Growth and Conidial Germination, but Not Sexual Reproduction
3.3. FgFAD12 Is Involved in Various Stress Responses
3.4. FgFAD12 Is Essential for Pathogen Virulence
3.5. Subcellular Localization of FgFad12 to the ER
3.6. Low Temperature Affects the Expression of Fatty Acid Desaturases
3.7. ∆Fgfad12 Mutant Is Defective in LA Formation
3.8. FgFad12 Affects Unsaturated Fatty Acid Biosynthesis
4. Discussion
5. Conclusions
Supplementary Materials
Author Contributions
Funding
Institutional Review Board Statement
Informed Consent Statement
Data Availability Statement
Acknowledgments
Conflicts of Interest
References
- Bai, G.; Shaner, G. Management and resistance in wheat and barley to fusarium head blight. Annu. Rev. Phytopathol. 2004, 42, 135–161. [Google Scholar] [CrossRef] [PubMed]
- Goswami, R.S.; Kistler, H.C. Heading for disaster: Fusarium graminearum on cereal crops. Mol. Plant Pathol. 2004, 5, 515–525. [Google Scholar] [CrossRef] [PubMed]
- Santiago, R.; Reid, L.M.; Arnason, J.T.; Zhu, X.; Martinez, N.; Malvar, R.A. Phenolics in maize genotypes differing in susceptibility to Gibberella stalk rot (Fusarium graminearum Schwabe). J. Agric. Food Chem. 2007, 55, 5186–5193. [Google Scholar] [CrossRef] [PubMed]
- Chen, Y.; Kistler, H.C.; Ma, Z. Fusarium graminearum Trichothecene Mycotoxins: Biosynthesis, Regulation, and Management. Annu. Rev. Phytopathol. 2019, 57, 15–39. [Google Scholar] [CrossRef] [PubMed]
- De Walle, J.V.; Sergent, T.; Piront, N.; Toussaint, O.; Schneider, Y.J.; Larondelle, Y. Deoxynivalenol affects in vitro intestinal epithelial cell barrier integrity through inhibition of protein synthesis. Toxicol. Appl. Pharmacol. 2010, 245, 291–298. [Google Scholar] [CrossRef] [PubMed]
- Desjardins, A.E.; Proctor, R.H. Molecular biology of Fusarium mycotoxins. Int. J. Food Microbiol. 2007, 119, 47–50. [Google Scholar] [CrossRef] [PubMed]
- Pestka, J.J. Deoxynivalenol: Mechanisms of action, human exposure, and toxicological relevance. Arch. Toxicol. 2010, 84, 663–679. [Google Scholar] [CrossRef] [PubMed]
- Dean, R.; Van Kan, J.A.; Pretorius, Z.A.; Hammond-Kosack, K.E.; Di Pietro, A.; Spanu, P.D.; Foster, G.D. The Top 10 fungal pathogens in molecular plant pathology. Mol. Plant Pathol. 2012, 13, 414–430. [Google Scholar] [CrossRef]
- Buerstmayr, H.; Ban, T.; Anderson, J.A. QTL mapping and marker-assisted selection for Fusarium head blight resistance in wheat. Plant Breed. 2009, 128, 1–26. [Google Scholar] [CrossRef]
- Kazan, K.; Gardiner, D.M. Transcriptomics of cereal-Fusarium graminearum interactions: What we have learned so far. Mol. Plant Pathol. 2018, 19, 764–778. [Google Scholar] [CrossRef]
- Liu, H.; Wang, Q.; He, Y.; Chen, L.; Hao, C.; Jiang, C.; Xu, J.R. Genome-wide A-to-I RNA editing in fungi independent of ADAR enzymes. Genome Res. 2016, 26, 499–509. [Google Scholar] [CrossRef] [PubMed]
- Liu, H.; Zhang, S.; Ma, J.; Dai, Y.; Li, C.; Lyu, X.; Xu, J.R. Two Cdc2 Kinase Genes with Distinct Functions in Vegetative and Infectious Hyphae in Fusarium graminearum. PLoS Pathog. 2015, 11, e1004913. [Google Scholar] [CrossRef][Green Version]
- Sridhar, P.S.; Trofimova, D.; Subramaniam, R.; González-Peña Fundora, D.; Foroud, N.A.; Allingham, J.S.; Loewen, M.C. Ste2 receptor-mediated chemotropism of Fusarium graminearum contributes to its pathogenicity against wheat. Sci. Rep. 2020, 10, 10770. [Google Scholar] [CrossRef]
- Wang, C.; Wang, Y.; Zhang, L.; Yin, Z.; Liang, Y.; Chen, L.; Zou, S. The Golgin Protein RUD3 Regulates Fusarium graminearum Growth and Virulence. Appl. Environ. Microbiol. 2021, 87, e02522-20. [Google Scholar] [CrossRef]
- Yang, B.; Wang, Y.; Tian, M.; Dai, K.; Zheng, W.; Liu, Z.; Wang, Y. Fg12 ribonuclease secretion contributes to Fusarium graminearum virulence and induces plant cell death. J. Integr. Plant Biol. 2021, 63, 365–377. [Google Scholar] [CrossRef] [PubMed]
- Zhang, Y.; Gao, X.; Sun, M.; Liu, H.; Xu, J.R. The FgSRP1 SR-protein gene is important for plant infection and pre-mRNA processing in Fusarium graminearum. Environ. Microbiol. 2017, 19, 4065–4079. [Google Scholar] [CrossRef]
- Klempova, T.; Mihalik, D.; Certik, M. Characterization of membrane-bound fatty acid desaturases. Gen. Physiol. Biophys. 2013, 32, 445–458. [Google Scholar] [CrossRef] [PubMed]
- Mishra, N.N.; Ali, S.; Shukla, P.K. Arachidonic acid affects biofilm formation and PGE2 level in Candida albicans and non-albicans species in presence of subinhibitory concentration of fluconazole and terbinafine. Braz. J. Infect. Dis. 2014, 18, 287–293. [Google Scholar] [CrossRef]
- Dong, W.; Chen, Y.; Zhang, Q.; Zhao, X.; Liu, P.; He, H.; Zhang, Y. Effects of lipoteichoic and arachidonic acids on the immune-regulatory mechanism of bovine mammary epithelial cells using multi-omics analysis. Front. Vet. Sci. 2022, 9, 984607. [Google Scholar] [CrossRef]
- Burdge, G.C. Is essential fatty acid interconversion an important source of PUFA in humans? Br. J. Nutr. 2019, 121, 615–624. [Google Scholar] [CrossRef]
- Dyall, S.C.; Balas, L.; Bazan, N.G.; Brenna, J.T.; Chiang, N.; da Costa Souza, F.; Taha, A.Y. Polyunsaturated fatty acids and fatty acid-derived lipid mediators: Recent advances in the understanding of their biosynthesis, structures, and functions. Prog Lipid Res. 2022, 86, 101165. [Google Scholar] [CrossRef] [PubMed]
- McKenzie, D.J.; Axelsson, M.; Chabot, D.; Claireaux, G.; Cooke, S.J.; Corner, R.A.; Metcalfe, J.D. Conservation physiology of marine fishes: State of the art and prospects for policy. Conserv. Physiol. 2016, 4, cow046. [Google Scholar] [CrossRef] [PubMed]
- Klempová, T.; Slaný, O.; Šišmiš, M.; Marcinčák, S.; Čertík, M. Dual production of polyunsaturated fatty acids and beta-carotene with Mucor wosnessenskii by the process of solid-state fermentation using agro-industrial waste. J. Biotechnol. 2020, 311, 1–11. [Google Scholar] [CrossRef] [PubMed]
- Nazir, Y.; Shuib, S.; Kalil, M.S.; Song, Y.; Hamid, A.A. Optimization of culture conditions for enhanced growth, lipid and docosahexaenoic acid (DHA) production of aurantiochytrium SW1 by response surface methodology. Sci. Rep. 2018, 8, 8909. [Google Scholar] [CrossRef] [PubMed]
- Takeno, S.; Sakuradani, E.; Tomi, A.; Inohara-Ochiai, M.; Kawashima, H.; Ashikari, T.; Shimizu, S. Improvement of the fatty acid composition of an oil-producing filamentous fungus, Mortierella alpina 1S-4, through RNA interference with delta12-desaturase gene expression. Appl. Environ. Microbiol. 2005, 71, 5124–5128. [Google Scholar] [CrossRef] [PubMed][Green Version]
- Dobryniewski, J.; Szajda, S.D.; Waszkiewicz, N.; Zwierz, K. Biology of essential fatty acids (EFA). Przegl. Lek. 2007, 64, 91–99. [Google Scholar]
- Huang, Y.S.; Chaudhary, S.; Thurmond, J.M.; Bobik, E.G., Jr.; Yuan, L.; Chan, G.M.; Knutzon, D.S. Cloning of delta12- and delta6-desaturases from Mortierella alpina and recombinant production of gamma-linolenic acid in Saccharomyces cerevisiae. Lipids 1999, 34, 649–659. [Google Scholar] [CrossRef]
- Maali-Amiri, R.; Goldenkova-Pavlova, I.V.; Yur’eva, N.O.; Pchelkin, V.P.; Tsydendambaev, V.D.; Vereshchagin, A.G.; Nosov, A.M. Lipid fatty acid composition of potato plants transformed with the Δ12-desaturase gene from cyanobacterium. Russ. J. Plant Physiol. 2007, 54, 600–606. [Google Scholar] [CrossRef]
- Calvo, A.M.; Hinze, L.L.; Gardner, H.W.; Keller, N.P. Sporogenic effect of polyunsaturated fatty acids on development of Aspergillus spp. Appl. Environ. Microbiol. 1999, 65, 3668–3673. [Google Scholar] [CrossRef]
- Tsitsigiannis, D.I.; Kowieski, T.M.; Zarnowski, R.; Keller, N.P. Three putative oxylipin biosynthetic genes integrate sexual and asexual development in Aspergillus nidulans. Microbiology (Reading) 2005, 151 Pt 6, 1809–1821. [Google Scholar] [CrossRef]
- Wang, C.; Zhang, S.; Hou, R.; Zhao, Z.; Zheng, Q.; Xu, Q.; Xu, J.R. Functional analysis of the kinome of the wheat scab fungus Fusarium graminearum. PLoS Pathog. 2011, 7, e1002460. [Google Scholar] [CrossRef]
- Hou, Z.; Xue, C.; Peng, Y.; Katan, T.; Kistler, H.C.; Xu, J.R. A mitogen-activated protein kinase gene (MGV1) in Fusarium graminearum is required for female fertility, heterokaryon formation, and plant infection. Mol. Plant Microbe Interact. 2002, 15, 1119–1127. [Google Scholar] [CrossRef]
- Zheng, Q.; Hou, R.; Zhang, J.; Ma, J.; Wu, Z.; Xu, J.R. The MAT locus genes play different roles in sexual reproduction and pathogenesis in Fusarium graminearum. PLoS ONE 2013, 8, e66980. [Google Scholar] [CrossRef]
- Catlett, N.L.; Lee, B.N.; Yoder, O.C.; Turgeon, B.G. Split-Marker Recombination for Efficient Targeted Deletion of Fungal Genes. Fungal Genet. Newsl. 2003, 50, 9–11. [Google Scholar] [CrossRef]
- Jiang, C.; Zhang, S.; Zhang, Q.; Tao, Y.; Wang, C.; Xu, J.R. FgSKN7 and FgATF1 have overlapping functions in ascosporogenesis, pathogenesis and stress responses in Fusarium graminearum. Environ. Microbiol. 2015, 17, 1245–1260. [Google Scholar] [CrossRef]
- Zheng, W.; Zhao, X.; Xie, Q.; Huang, Q.; Zhang, C.; Zhai, H.; Wang, Z. A conserved homeobox transcription factor Htf1 is required for phialide development and conidiogenesis in Fusarium species. PLoS ONE 2012, 7, e45432. [Google Scholar] [CrossRef]
- Wang, G.; Wang, C.; Hou, R.; Zhou, X.; Li, G.; Zhang, S.; Xu, J.R. The AMT1 arginine methyltransferase gene is important for plant infection and normal hyphal growth in Fusarium graminearum. PLoS ONE 2012, 7, e38324. [Google Scholar] [CrossRef]
- Bluhm, B.H.; Zhao, X.; Flaherty, J.E.; Xu, J.R.; Dunkle, L.D. RAS2 regulates growth and pathogenesis in Fusarium graminearum. Mol. Plant Microbe Interact. 2007, 20, 627–636. [Google Scholar] [CrossRef]
- Zhang, X.W.; Jia, L.J.; Zhang, Y.; Jiang, G.; Li, X.; Zhang, D.; Tang, W.H. In planta stage-specific fungal gene profiling elucidates the molecular strategies of Fusarium graminearum growing inside wheat coleoptiles. Plant Cell 2012, 24, 5159–5176. [Google Scholar] [CrossRef] [PubMed]
- Seong, K.; Hou, Z.; Tracy, M.; Kistler, H.C.; Xu, J.R. Random Insertional Mutagenesis Identifies Genes Associated with Virulence in the Wheat Scab Fungus Fusarium graminearum. Phytopathology 2005, 95, 744–750. [Google Scholar] [CrossRef] [PubMed]
- Zhao, Z.; Liu, H.; Luo, Y.; Zhou, S.; An, L.; Wang, C.; Xu, J.R. Molecular evolution and functional divergence of tubulin superfamily in the fungal tree of life. Sci. Rep. 2014, 4, 6746. [Google Scholar] [CrossRef]
- Livak, K.J.; Schmittgen, T.D. Analysis of relative gene expression data using real-time quantitative PCR and the 2(-Delta Delta C(T)) Method. Methods 2001, 25, 402–408. [Google Scholar] [CrossRef]
- King, R.; Urban, M.; Hammond-Kosack, M.C.; Hassani-Pak, K.; Hammond-Kosack, K.E. The completed genome sequence of the pathogenic ascomycete fungus Fusarium graminearum. BMC Genom. 2015, 16, 544. [Google Scholar] [CrossRef]
- Kim, D.; Langmead, B.; Salzberg, S.L. HISAT: A fast spliced aligner with low memory requirements. Nat. Methods 2015, 12, 357–360. [Google Scholar] [CrossRef]
- Pertea, M.; Pertea, G.M.; Antonescu, C.M.; Chang, T.C.; Mendell, J.T.; Salzberg, S.L. StringTie enables improved reconstruction of a transcriptome from RNA-seq reads. Nat. Biotechnol. 2015, 33, 290–295. [Google Scholar] [CrossRef]
- Cuomo, C.A.; Güldener, U.; Xu, J.R.; Trail, F.; Turgeon, B.G.; Di Pietro, A.; Kistler, H.C. The Fusarium graminearum genome reveals a link between localized polymorphism and pathogen specialization. Science 2007, 317, 1400–1402. [Google Scholar] [CrossRef]
- Chou, K.C.; Shen, H.B. A new method for predicting the subcellular localization of eukaryotic proteins with both single and multiple sites: Euk-mPLoc 2.0. PLoS ONE 2010, 5, e9931. [Google Scholar] [CrossRef]
- Velly, H.; Bouix, M.; Passot, S.; Penicaud, C.; Beinsteiner, H.; Ghorbal, S.; Fonseca, F. Cyclopropanation of unsaturated fatty acids and membrane rigidification improve the freeze-drying resistance of Lactococcus lactis subsp. lactis TOMSC161. Appl. Microbiol. Biotechnol. 2015, 99, 907–918. [Google Scholar] [CrossRef]
- Wang, J.; Zeng, W.; Cheng, J. lncRsp1, a long noncoding RNA, influences Fgsp1 expression and sexual reproduction in Fusarium graminearum. Mol. Plant Pathol. 2022, 23, 265–277. [Google Scholar] [CrossRef] [PubMed]
- Lee, J.M.; Lee, H.; Kang, S.; Park, W.J. Fatty acid desaturases, polyunsaturated fatty acid regulation, and biotechnological advances. Nutrients 2016, 8, 23. [Google Scholar] [CrossRef] [PubMed]
- Espenshade, P.J.; Hughes, A.L. Regulation of sterol synthesis in eukaryotes. Annu. Rev. Genet. 2007, 41, 401–427. [Google Scholar] [CrossRef]
- Wollam, J.; Antebi, A. Sterol regulation of metabolism, homeostasis, and development. Annu. Rev. Biochem. 2011, 80, 885–916. [Google Scholar] [CrossRef]
- Lees, N.D.; Bard, M.; Kirsch, D.R. Biochemistry and molecular biology of sterol synthesis in Saccharomyces cerevisiae. Critl. Rev. Biochem. Mol. Biol. 1999, 34, 33–47. [Google Scholar]
- Stieger, B.; Steiger, J.; Locher, K.P. Membrane lipids and transporter function. Biochim. Biophys. Acta Mol. Basis Dis. 2021, 1867, 166079. [Google Scholar] [CrossRef]
- Massey, K.A.; Nicolaou, A. Lipidomics of polyunsaturated-fatty-acid-derived oxygenated metabolites. Biochem. Soc. Trans. 2011, 39, 1240–1246. [Google Scholar] [CrossRef]
- Tezaki, S.; Iwama, R.; Kobayashi, S.; Shiwa, Y.; Yoshikawa, H.; Ohta, A.; Fukuda, R. Δ12-fatty acid desaturase is involved in growth at low temperature in yeast Yarrowia lipolytica. Biochem. Biophys. Res. Commun. 2017, 488, 165–170. [Google Scholar] [CrossRef]
- Wilson, R.A.; Calvo, A.M.; Chang, P.K.; Keller, N.P. Characterization of the Aspergillus parasiticus delta12-desaturase gene: A role for lipid metabolism in the Aspergillus-seed interaction. Microbiology (Reading) 2004, 150 Pt 9, 2881–2888. [Google Scholar] [CrossRef]
- Calvo, A.M.; Gardner, H.W.; Keller, N.P. Genetic connection between fatty acid metabolism and sporulation in Aspergillus nidulans. J. Biol. Chem. 2001, 276, 25766–25774. [Google Scholar] [CrossRef]
- Peyou-Ndi, M.M.; Watts, J.L.; Browse, J. Identification and characterization of an animal delta (12) fatty acid desaturase gene by heterologous expression in Saccharomyces cerevisiae. Arch. Biochem. Biophys. 2000, 376, 399–408. [Google Scholar] [CrossRef] [PubMed]
- Derkacz, D.; Bernat, P.; Krasowska, A. K143R Amino Acid Substitution in 14-α-Demethylase (Erg11p) Changes Plasma Membrane and Cell Wall Structure of Candida albicans. Int. J. Mol. Sci. 2022, 23, 1631. [Google Scholar] [CrossRef] [PubMed]
- Zhang, M.; Liu, Z.; Yu, Q.; Mao, J.; Zhang, B.; Xing, L.; Li, M. Deletion of genes encoding fatty acid desaturases leads to alterations in stress sensitivity in Pichia pastoris. FEMS Yeast Res. 2015, 15, fov020. [Google Scholar] [CrossRef]
- Lu, H.; Zhang, X.; Li, J.; Tg, L.E.I. Effects of adversity on fatty acid composition in fungal membrane. J. Microbiol. 2005, 25, 1–3. [Google Scholar]
- Alonso, L.; Menegatti, R.; Dorta, M.L.; Alonso, A. Plasma membrane rigidity effects of 4-hydroxy-2-nonenal in Leishmania, erythrocyte and macrophage. Toxicol. In Vitro 2022, 79, 105294. [Google Scholar] [CrossRef]
- Lepesheva, G.I.; Waterman, M.R. Sterol 14alpha-demethylase cytochrome P450 (CYP51), a P450 in all biological kingdoms. Biochim. Biophys. Acta 2007, 1770, 467–477. [Google Scholar] [CrossRef]
- Parks, L.W.; Smith, S.J.; Crowley, J.H. Biochemical and physiological effects of sterol alterations in yeast—A review. Lipids 1995, 30, 227–230. [Google Scholar] [CrossRef]
- DeJarnette, C.; Meyer, C.J.; Jenner, A.R.; Butts, A.; Peters, T.; Cheramie, M.N.; Lee, R.E. Identification of inhibitors of fungal fatty acid biosynthesis. ACS Infect. Dis. 2021, 7, 3210–3223. [Google Scholar] [CrossRef]
- Nguyen, L.N.; Trofa, D.; Nosanchuk, J.D. Fatty acid synthase impacts the pathobiology of Candida parapsilosis in vitro and during mammalian infection. PLoS ONE 2009, 4, e8421. [Google Scholar] [CrossRef]
- Xu, D.; Sillaots, S.; Davison, J.; Hu, W.; Jiang, B.; Kauffman, S.; Roemer, T. Chemical genetic profiling and characterization of small-molecule compounds that affect the biosynthesis of unsaturated fatty acids in Candida albicans. J. Biol. Chem. 2009, 284, 19754–19764. [Google Scholar] [CrossRef]
- Boedi, S.; Berger, H.; Sieber, C.; Münsterkötter, M.; Maloku, I.; Warth, B.; Strauss, J. Comparison of Fusarium graminearum transcriptomes on living or dead wheat differentiates substrate-responsive and defense-responsive genes. Front. Microbiol. 2016, 7, 1113. [Google Scholar] [CrossRef]
- Brown, N.A.; Antoniw, J.; Hammond-Kosack, K.E. The predicted secretome of the plant pathogenic fungus Fusarium graminearum: A refined comparative analysis. PLoS ONE 2012, 7, e33731. [Google Scholar] [CrossRef]
- Hsieh, S.L.; Kuo, C.M. Stearoyl-CoA desaturase expression and fatty acid composition in milkfish (Chanos chanos) and grass carp (Ctenopharyngodon idella) during cold acclimation. Comp. Biochem. Physiol. B Biochem. Mol. Biol. 2005, 141, 95–101. [Google Scholar] [CrossRef]
- Wongwathanarat, P.; Michaelson, L.V.; Carter, A.T.; Lazarus, C.M.; Griffiths, G.; Stobart, A.K.; MacKenzie, D.A. Two fatty acid delta9-desaturase genes, ole1 and ole2, from Mortierella alpina complement the yeast ole1 mutation. Microbiology (Reading) 1999, 145 Pt 10, 2939–2946. [Google Scholar] [CrossRef][Green Version]
- Okuda, T.; Ando, A.; Negoro, H.; Muratsubaki, T.; Kikukawa, H.; Sakamoto, T.; Sakuradani, E.; Shimizu, S.; Ogawa, J. Eicosapentaenoic acid (EPA) production by an oleaginous fungus Mortierella alpina expressing heterologous the Delta 17-desaturase gene under ordinary temperature. Eur. J. Lipid Sci. Tech. 2015, 117, 1919–1927. [Google Scholar] [CrossRef]
- Okuda, T.; Ando, A.; Negoro, H.; Kikukawa, H.; Sakamoto, T.; Sakuradani, E.; Ogawa, J. Omega-3 eicosatetraenoic acid production by molecular breeding of the mutant strain S14 derived from Mortierella alpina 1S-4. J. Biosci. Bioeng. 2015, 120, 299–304. [Google Scholar] [CrossRef]
- Kosa, G.; Zimmermann, B.; Kohler, A.; Ekeberg, D.; Afseth, N.K.; Mounier, J.; Shapaval, V. High-throughput screening of Mucoromycota fungi for production of low- and high-value lipids. Biotechnol. Biofuels 2018, 11, 66. [Google Scholar] [CrossRef]
- He, J.; Yang, Z.; Hu, B.; Ji, X.; Wei, Y.; Lin, L.; Zhang, Q. Correlation of polyunsaturated fatty acids with the cold adaptation of Rhodotorula glutinis. Yeast 2015, 32, 683–690. [Google Scholar] [CrossRef]
- Tan, L.; Zhuo, R.; Li, S.; Ma, F.; Zhang, X. Differential expression of desaturase genes and changes in fatty acid composition of Mortierella sp. AGED in response to environmental factors. J. Sci. Food Agric. 2017, 97, 1876–1884. [Google Scholar] [CrossRef]

| Strain | Brief Description | References |
|---|---|---|
| PH-1 | Wild type | [46] |
| ∆Fgfad12 | Fgfad12 deletion mutant of PH-1 | This study |
| ∆FgFad12-C | Fgfad12/FgFAD12-GFP transformant of ∆Fgfad12 | This study |
| CL3 | FgFAD12-GFP and FgKAR2-mCherry transformant of PH-1 | This study |
| Strain | Growth Rate a (mm/d) | Conidiation b (×106/mL) | Disease Index c | DON (ppm) d |
|---|---|---|---|---|
| PH-1 | 12.1 ± 0.1 A | 1.5 ± 0.4 A | 15.2 ± 1.4 A | 718.5 ± 74.3 A |
| ∆Fgfad12 | 6.0 ± 0.2 B | 1.6 ± 0.3 B | 3.2 ± 1.1 B | 103.0 ± 27.7 B |
| ∆FgFad12-C | 12.1 ± 0.1 A | 1.5 ± 0.2 A | 14.6 ±1.1 A | 709.5 ± 49.4 A |
| Content of Fatty Acids (μg/mg) | ||||||
|---|---|---|---|---|---|---|
| Strain | Capric Acid (C10:0) | Palmitic Acid (C16:0) | Stearic Acid (C18:0) | Oleic Acid (C18:1) | Linoleic Acid (C18:2) | Linolenic Acid (C18:3) |
| PH-1 | 0.13 ± 0.03 | 4.03 ± 0.11 | 1.20 ± 0.12 | 4.91 ± 0.17 | 14.66 ± 0.05 | 8.68 ± 0.13 |
| ∆FgFad12 | 0.11 ± 0.04 | 3.92 ± 0.49 | 1.42 ± 0.40 | 56.30 ± 0.67 | 0 | 1.23 ± 0.18 |
Disclaimer/Publisher’s Note: The statements, opinions and data contained in all publications are solely those of the individual author(s) and contributor(s) and not of MDPI and/or the editor(s). MDPI and/or the editor(s) disclaim responsibility for any injury to people or property resulting from any ideas, methods, instructions or products referred to in the content. |
© 2024 by the authors. Licensee MDPI, Basel, Switzerland. This article is an open access article distributed under the terms and conditions of the Creative Commons Attribution (CC BY) license (https://creativecommons.org/licenses/by/4.0/).
Share and Cite
Zhang, Y.; Gao, Z.; Lei, Y.; Song, L.; He, W.; Liu, J.; Song, M.; Dai, Y.; Yang, G.; Gong, A. FgFAD12 Regulates Vegetative Growth, Pathogenicity and Linoleic Acid Biosynthesis in Fusarium graminearum. J. Fungi 2024, 10, 288. https://doi.org/10.3390/jof10040288
Zhang Y, Gao Z, Lei Y, Song L, He W, Liu J, Song M, Dai Y, Yang G, Gong A. FgFAD12 Regulates Vegetative Growth, Pathogenicity and Linoleic Acid Biosynthesis in Fusarium graminearum. Journal of Fungi. 2024; 10(4):288. https://doi.org/10.3390/jof10040288
Chicago/Turabian StyleZhang, Yimei, Zhen Gao, Yinyu Lei, Liuye Song, Weijie He, Jingrong Liu, Mengge Song, Yafeng Dai, Guang Yang, and Andong Gong. 2024. "FgFAD12 Regulates Vegetative Growth, Pathogenicity and Linoleic Acid Biosynthesis in Fusarium graminearum" Journal of Fungi 10, no. 4: 288. https://doi.org/10.3390/jof10040288
APA StyleZhang, Y., Gao, Z., Lei, Y., Song, L., He, W., Liu, J., Song, M., Dai, Y., Yang, G., & Gong, A. (2024). FgFAD12 Regulates Vegetative Growth, Pathogenicity and Linoleic Acid Biosynthesis in Fusarium graminearum. Journal of Fungi, 10(4), 288. https://doi.org/10.3390/jof10040288






